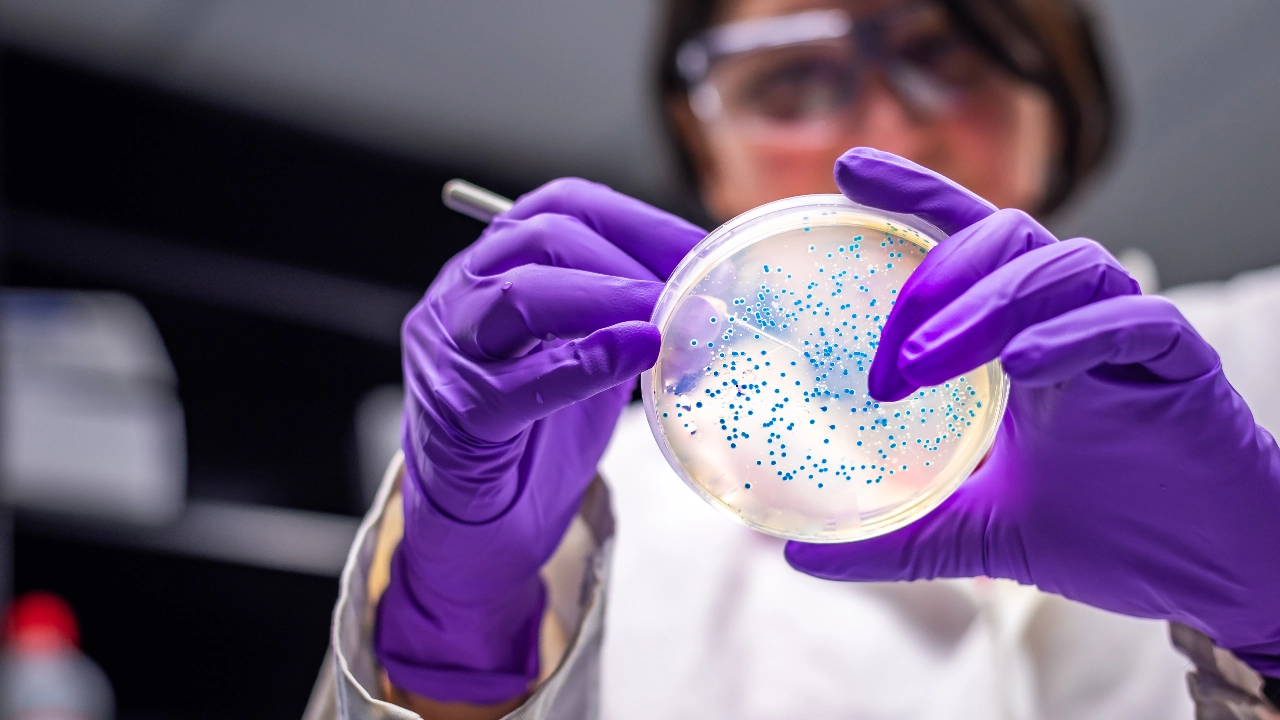

เชื้อ Superbugs (ซุปเปอร์บั๊ก) หรือโรคดื้อยา เป็นหนึ่งในภัยคุกคามที่คร่าชีวิต และส่งผลต่อสุขภาพประชากรโลกที่เพิ่มมากขึ้นต่อในทุกปี ล่าสุดนักวิทยาศาสตร์ จากมหาวิทยาลัยฮาร์วาร์ด ได้ค้นพบคำตอบที่ช่วยให้เราเอาชนะการต่อสู้กับ Superbugs ได้ พร้อมพัฒนายาปฏิชีวนะ และวิธีรับมือใหม่ที่ช่วยป้องกันโรคดื้อยานี้อย่างทันในอนาคต
เชื้อ Superbugs (ซุปเปอร์บั๊ก) เชื้อโรคสุดแข็งแกร่งที่สามารถพัฒนาตนเอง เพื่อต่อต้านยาปฏิชีวนะต่างๆ ได้ Superbugs คือ ชื่อเรียก ‘เชื้อโรค’ ต่อต้านยาปฏิชีวนะทั้ง 4 ประเภท เช่น แบคทีเรีย เชื้อรา พยาธิ ไวรัส โดยเชื้อโรคเหล่านี้มีการพัฒนาตนเองเพื่อต่อต้านยาปฏิชีวนะ ทำให้ยากต่อการรักษา และต้องคอยติดตามผลรักษาอย่างระมัดระวัง ซึ่งสร้างความวิตกกังวลให้วงการแพทย์ในการรักษาโรคต่างๆ มาอย่างเนิ่นนาน (รู้จัก Superbugs เพิ่มมากขึ้นได้ที่นี่)
เชื้อราซุปเปอร์บั๊ก จึงถือเป็นภัยคุกคามที่เพิ่มมากขึ้นต่อสุขภาพประชากรโลก เคยมีอัตราระบาดสูงขึ้นหลังจากโรคโควิด-19 เนื่องจากการใช้ยารักษาตนเองเพิ่มขึ้น ความเครียด และการใช้ชีวิต ซึ่งทำให้เชื้อโรคเหล่านี้มีการพัฒนาตัวเองอย่างรวดเร็ว มีอัตราทำให้เกิดการเสียชีวิตมากกว่า 1 ล้านคนในแต่ละปี และอาจคร่าชีวิตผู้คนได้มากสูงสุด 10 ล้านคนในปี 2050
วงการแพทย์มองว่าการดื้อยาของ Superbug ชนิดที่เป็น ‘เชื้อแบคทีเรีย’ มีความน่าเป็นห่วงที่สุด เพราะเมื่อเกิดอาการซุปเปอร์บั๊กแล้ว มีผลให้ยาปฏิชีวนะตัวเดิมไม่เป็นผล ทำให้แพทย์ต้องเปลี่ยนตัวยาไปเรื่อยๆ พร้อมกับการพัฒนายาปฏิชีวนะตัวใหม่เพื่อต่อสู้กับเชื้อโรคซุปปอร์บั๊กสายพันธุ์ที่เป็นแบคทีเรีย ซึ่งพัฒนาตนเองได้อย่างรวดเร็ว

...
ล่าสุดนักวิทยาศาสตร์ จากมหาวิทยาลัยฮาร์วาร์ด ได้ค้นพบคำตอบที่ช่วยให้เราเอาชนะการต่อสู้กับ Superbugs ได้ ด้วยสารประกอบสังเคราะห์ชนิดใหม่ที่ชื่อว่า Cresomycin แสดงให้เห็นว่าสามารถฆ่าเชื้อซุปเปอร์บั๊กชนิดแบคทีเรียที่ดื้อยาได้หลายสายพันธุ์
ปกติแล้วยาปฏิชีวนะส่วนใหญ่ทำงาน โดยกำหนดลักษณะ และชนิดของสายพันธุ์ และเซลล์ของเชื้อโรคและแบคทีเรียไว้อย่างชัดเจน สิ่งนั้นเรียกว่า ไรโบโซม (Ribosomes) เป็นสารโมเลกุลขนาดเล็กที่จำเป็นสำหรับการเจริญเติบโตของเซลล์เชื้อตัวนั้นๆ เพื่อป้องกันแบคทีเรีย แต่อย่างไรก็ตามแบคทีเรียบางสายพันธุ์สามารถพัฒนาตัวเองให้เข้ากับการเจริญเติบโตของเซลล์ที่ป้องกัน และฝ่าด่านไปได้ มีผลทำให้ ไรโบโซม หยุดการทำงานโดยทันที จนเกิดการดื้อยา
Cresomycin จึงเป็นสารที่คิดค้นขึ้นมาเพื่อป้องกันการฝ่าเข้าไปฝั่ง กลมกลืม และเจริญเติบโตของเชื้อโรคเหล่านี้โดยเฉพาะ โดยจะเข้าไปยึดเกาะกับตัวไรโบโซมได้ดีกว่า ยาปฏิชีวนะอื่นๆ ทั่วไป
นอกจากนี้ยังมีการใช้เทคโนโลยีทางการแพทย์ และ AI เพื่อค้นหาการขยายพันธุ์ของเชื้อโรคใหม่ๆ ที่จะเกิดขึ้น เพื่อทำยาปฏิชีวนะ และวิธีรับมือใหม่ๆ ในอนาคตช่วงอีก 60 ปีข้างหน้า โดยเน้นเป็นการวิจัยตัว MRSA Superbugs เป็นซุปเปอร์บั๊กที่คร่าชีวิตผู้คนมากกว่า 100,000 คนในแต่ละปี เพื่อการพัฒนาการป้องกันใหม่ๆ ให้ทันกับโรคดื้อยานี้อย่างทันถ่วงที
ข้อมูล : worldeconomicforum
ภาพ : istock